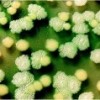
pseudomonas_small (credit: Hemantha Kulasekara)

A small Johns Hopkins Children’s Center study of children and teens with cystic fibrosis (CF) shows that simple exercise, individually tailored to each patient’s preference and lifestyle, can help improve lung function and overall fitness. Frequent lung infections, breathing problems, and decreased lung function are the hallmark symptoms of CF, a genetic disorder marked by […]

Recent Comments